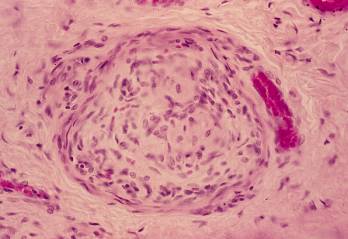

子宮15. 陰部神経小体.
ヒト、フォルマリン固定、セロイディン包埋、H-E染色、x 300.(図14の拡大).
これは陰核(図14)の尖端に近い部分に見られた陰部神経小体である。陰部---
神経小体は周囲を皮膜で包まれた特殊な知覚神経終末で、外陰部の皮下組織内
に散在する。---------------------------------------------------------------------------------------
Uterus
15.
Human, fixation with formalin, embedding with celloidin, H-E stain, x 300.
This
is a Corpuscula genitalis, found in the subcutaneous connective tissue--
of
the clitoris shown in Figure 14. The corpuscula genitalis is a special--------
encapsulated type of the sensory nerve endings found in the external genital
organs.-----------------------------------------------------------------------------------------------